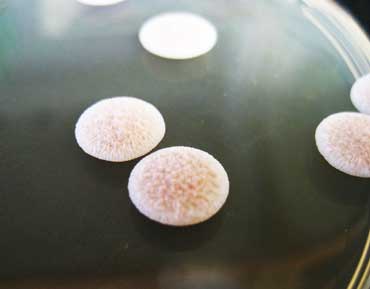

Wild yeasts are brewing up batches of trendy beers
Using scavenged microbes for fermentation brings out the funky and sour flavors
MICROBE BREWS Scientists are looking for a few good yeasts to enhance beer brewing. Each flask (above) contains the same liquid ingredients and a different kind of yeast.
M. Bochman
- More than 2 years ago
Craft brewers are going wild. Some of the trendiest beers on the market are intentionally brewed to be sour and funky. One of the hottest new ingredients in the beverages: Yeast scavenged from nature.
Unlike today’s usual brewing, which typically relies on carefully cultivated ale or lager yeast and rejects outsider microbes, some brewers are returning to beer’s roots. Those beginnings go back thousands of years and for most of that time, the microbes fermenting grain into alcohol were probably wild yeast and bacteria that fell into the brew. Now local microbes — in some cases with the help of scientists — are being welcomed back into breweries.
Wild and sour beers are a niche, but growing segment of the craft brewing market, says Bart Watson, chief economist of the Brewers Association. Last year, more than 245,000 cases of wild and sour beers were sold and sales are up 9 percent so far this year.
For geneticist Maitreya Dunham, wild, funky and sour beers aren’t just a market trend; they are ecological microcosms. Dunham’s lab group at the University of Washington in Seattle uses yeast to study genetic variation and evolution. She got interested in beer when her husband took up home brewing.

Dunham teamed up with a brewer who made a wild beer with microbes from a warehouse. “Whatever is living in the old warehouse ended up in the beer,” she says. On a lab outing to the brewery, Dunham and her team took samples from beer barrels, marveling at the thriving mass of microbes gurgling inside. “You could see it being alive in there.”
DNA tests revealed that four kinds of bacteria and four kinds of yeast, including a newly identified hybrid yeast, lived in the wild brew, Dunham and colleagues reported June 15 on bioRxiv.org. The hybrid doesn’t have a name yet, because Dunham is still trying to identify its parents. One is Pichia membranifaciens, but the other is an unknown fungus P. membranifaciens is a food spoiler, and no lightweight: It can handle up to 11 percent alcohol. The other parent’s identity and attributes aren’t known, and that ID can take time. People have known for a long time that lager yeast Saccharomyces pastorianus is a hybrid, but scientists didn’t identify both of its parents until 2011.
As excited as Dunham is to find a hybrid yeast, she’s not sure that it will take beer brewing by storm. Her lab brewed a small batch of “science beer” with the hybrid yeast. The yeast didn’t make much ethanol or other flavor compounds. “It didn’t do much on its own,” she laments. But she hasn’t given up hope. Sometimes a yeast needs bacteria or other fungi to really shine. Maybe, she says, “when it’s mixed in with all its friends, it may bring something interesting to the party.”
A Facebook group of home brewers called Milk the Funk is about to help her find out. People from the group saw Dunham’s study on bioRxiv.org and volunteered to ferment beers with and without the hybrid. “I’m about to have a couple dozen people doing experiments for me,” Dunham says. “In fact, they’re going to send me free beer, although it may be weird beer.” (“Funk is one of the flavors they go for in these weirdo beers,” Dunham explains. Descriptions of funk encompass barnyard tastes and smells such as goat, horse blanket, urine, sweat, cheese and manure, as well as spicy notes and complex flavors of clove, smoke, Band-Aid, bacon and bitter, says fellow scientist and yeast hunter Matthew Bochman. “Funk basically covers anything ‘weird’ in beer that might be interesting or pleasant in small amounts but off-putting at higher concentrations.”)

In 2014, he met brewer Robert Caputo, who wanted to make an all-Indiana beer. There were farmers in the state growing hops and malt grains. Indiana water was plentiful. “The missing ingredient was the Indiana yeast,” Bochman says. Caputo asked Bochman to help him find the missing microbe. “So we went yeast hunting.”
That spring and summer, Bochman collected about 100 strains of yeast. “Whenever I was out and about I would grab something — a piece of a bark, a berry — bring it back to the lab and get yeast from it.” The microbes are everywhere, he says. “It’s hard not to find yeast.”
But not just any yeast will do. For beer brewing, he needed to find yeast that eat the sugar maltose in the wort — the liquid extracted from grain mash that will be fermented into beer. Yeasts used for brewing also have to be tolerant of hops, which make weak acids that might slow yeast growth. The yeast must be able to live in 4 to 5 percent alcohol. In addition, the microbes have “to smell and taste at least neutral, if not good,” Bochman said.
Not all yeast can pass the sniff test. For instance, eight strains of Saccharomyces paradoxus “all smelled and tasted heavily of adhesive bandages,” Bochman and colleagues reported August 7 on bioRxiv.org.
But in 2015, a batch of wild beer brewed in an open vat in a vacant lot in Indianapolis by Bochman’s friends at Black Acre Brewing Co., yielded a winner. Among the four species and six strains of yeast in the beer was a Saccharomyces cerevisiae strain called YH166. S. cerevisiae is the species of yeast used to brew ales and wine and to make bread. YH166 lends beer an aroma that is “an amazing pineapple, guava something. Like an umbrella drink,” says Bochman.
He doesn’t yet know what chemicals the yeast makes to produce the tropical fruit scent. He puts his money on one of the sweet-smelling esters yeast use to attract the fruit flies that can give the fungi a lift — sort of a microbial version of a ride-hailing app.
Among 54 species of yeasts Bochman and colleagues investigated, he found five strains that can make both alcohol and lactic acid to brew sour beers without troublesome bacteria. The researchers described the five sourpusses — Hanseniaspora vineae, Lachancea fermentati, Lachancea thermotolerans, Schizosaccharomyces japonicus and Wickerhamomyces anomalus — July 28 on bioRxiv.org. Bochman and Caputo formed Wild Pitch Yeast, a company to sell the strains, in part, to fund his yeast research. The company supplied yeasts isolated from cobwebs, trees and other spots to brewers for making all-Indiana beers, dubbed “Bicentenni-ales” in honor of the state’s 200th anniversary.
Both Bochman and Dunham are relying on brewers to tell them how their newfound yeast perform in the real world. “The proof is in the brewing,” Bochman says. “You can do as many lab tests as you want, but you’re never going to know how something will act until you throw it into some wort and let it bubble away for a couple of weeks.”
![]() |
Tina Hesman Saey is the molecular biology reporter and senior staff writer for Science News. She has a Ph.D. in molecular genetics from Washington University in St. Louis and a master’s in science journalism from Boston University. Tina previously covered biotechnology, genetics and medical science for the St. Louis Post-Dispatch. Read more » | |
| About this bio | ||
![]() | |
| Tina Hesman Saey is the molecular biology reporter and senior staff writer for Science News. She has a Ph.D. in molecular genetics from Washington University in St. Louis and a master’s in science journalism from Boston University. Tina previously covered biotechnology, genetics and medical science for the St. Louis Post-Dispatch. Read more » | |
| About this bio | |
